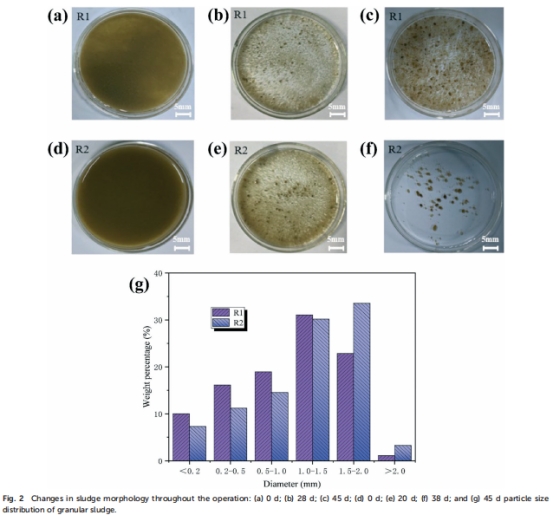

熱線:021-66110810,66110819
手機:13564362870

熱線:021-66110810,66110819
手機:13564362870
Alternating aeration strategy to reduce aeration energy demand for aerobic granular sludge and analysis of microbial community dynamics
減少好氧顆粒污泥曝氣能量需求的交替曝氣策略以及微生物群落動態分析
來源:Environ. Sci.: Water Res.Technol., 2022, 8, 1111
摘要核心內容
本研究提出一種創新的交替曝氣策略,通過對比傳統連續曝氣(R1)與交替曝氣(R2)在好氧顆粒污泥(AGS)反應器中的效果,證明交替曝氣可加速污泥顆粒化(提前8天)、降低能耗33%,同時維持高效脫氮能力(TN去除率71.32%)。關鍵發現包括:
顆粒化加速:R2在20天出現顆粒雛形(圖2e),38天形成成熟AGS(粒徑1.5-2.0 mm),結構致密(圖2f);
脫氮提升:交替曝氣創造缺氧環境,促進同步硝化反硝化(SND),TN去除率較R1提高9.67%(圖4c);

微生物調控:交替曝氣富集功能菌屬(Zoogloea和Thauera),分泌EPS促進顆粒穩定性(圖7c);

節能效益:曝氣時間減少33%,DO動態監測顯示停曝期DO驟降(1.24 mg/L),驅動反硝化(圖5c)。

研究目的
降低能耗:解決傳統AGS技術因連續曝氣導致的高能耗問題(占污水處理廠總能耗50-70%);
強化脫氮:通過曝氣調控優化缺氧/好氧環境,提升TN去除效率;
解析微生物機制:揭示交替曝氣對微生物群落結構及功能的影響。
研究思路
采用平行反應器對照實驗:
反應器設計:
R1:連續曝氣(210 min/周期,DO=4-5 mg/L);
R2:交替曝氣(50 min曝氣 + 40 min停曝,循環3次,DO波動1.24-5.2 mg/L)(圖1);

監測指標:
污泥特性:粒徑分布(圖2g)、沉降性(SVI,圖3)、EPS分泌;

水質參數:COD、NH??-N、TN、PO?3?-P(圖4);
微生物群落:高通量測序(門/屬水平,圖6-7);

DO動態:Unisense微電極實時監測(圖5c);
操作變量:逐步縮短沉降時間(20→3 min),強化顆粒選擇壓力。
測量數據及其研究意義
1. 污泥特性與沉降性(圖2-3)
數據來源:
粒徑分布:R2顆粒(1.5-2.0 mm占比63.71%)較R1(53.86%)更均勻(圖2g);
沉降性:R2的SVI降至38.8 mL/g(R1為41.83 mL/g),污泥濃度(MLSS)達4.72 g/L(圖3);
研究意義:證實交替曝氣通過"饑飽交替"刺激EPS分泌,加速顆粒化并提升結構穩定性。
2. 水質去除性能(圖4)
數據來源:
COD去除:R2達93.72%(R1為91.71%),停曝期促進厭氧代謝(圖4a);
TN去除:R2達71.32%(R1為61.65%),停曝期DO<1.5 mg/L驅動反硝化(圖4c);
PO?3?-P去除:R2達82.21%(R1為80.16%),富集PAOs(圖4d);
研究意義:交替曝氣優化了碳源利用(反硝化耗碳減少),提升脫氮除磷協同性。
3. DO動態與微生物活動(圖5c)
數據來源:
DO曲線:停曝40 min內DO從5.2 mg/L降至1.24 mg/L,創造瞬時缺氧環境(圖5c);
脫氮關聯:DO低谷期(<1.5 mg/L)對應NO??-N濃度下降(圖5b);
研究意義:Unisense電極捕捉到DO瞬態變化,揭示"曝氣-停曝"循環如何通過DO梯度調控SND。
4. 微生物群落結構(圖6-7)
數據來源:
優勢菌門:Proteobacteria(74.1%)、Bacteroidetes(7.98%)主導(圖7a);
功能菌屬:R2富集Zoogloea(19.46%,分泌EPS)和Thauera(3.9%,反硝化)(圖7c);
研究意義:交替曝氣塑造功能菌群,Zoogloea促顆粒化,Thauera強化脫氮。
結論
節能與效能平衡:交替曝氣減少曝氣時間33%,TN去除率提升至71.32%,破解AGS高能耗瓶頸;
顆粒化機制:停曝期創造缺氧環境,刺激EPS分泌(Zoogloea)和反硝化(Thauera),加速顆粒成熟;
工程應用:該策略適用于主流污水處理,可降低運營成本20-30%(據能耗計算)。
Unisense電極數據的專項解讀
技術原理
Unisense DO微電極(OX-10型)以高時空分辨率(秒級響應)監測反應器內DO梯度:
動態捕捉:實時記錄曝氣/停曝轉換中DO驟降過程(5.2 → 1.24 mg/L in 40 min,圖5c);
空間關聯:DO低谷與NO??-N下降同步,證實缺氧期觸發反硝化。
科學價值
揭示SND機制:DO<1.5 mg/L時,顆粒內部形成"好氧外殼/缺氧核心",實現同步硝化反硝化;
優化曝氣控制:明確停曝時長閾值(≥40 min)以保證充分反硝化,避免NO??累積;
微生物-環境耦合:DO瞬態變化驅動Thauera富集,建立功能菌群與操作參數的定量關聯。
工程意義
工藝調控:基于DO動態設定曝氣周期(如50 min開/40 min關),避免過度曝氣;
N?O減排:減少停曝末期DO過低(<0.5 mg/L)導致的N?O釋放風險;
放大設計:為全尺寸AGS廠提供DO控制參數(停曝期DO維持在1.0-1.5 mg/L)。
總結:Unisense電極通過高分辨率DO監測,揭示了交替曝氣中"瞬時缺氧"驅動脫氮的機制,為節能型AGS工藝提供了理論依據和調控基準。